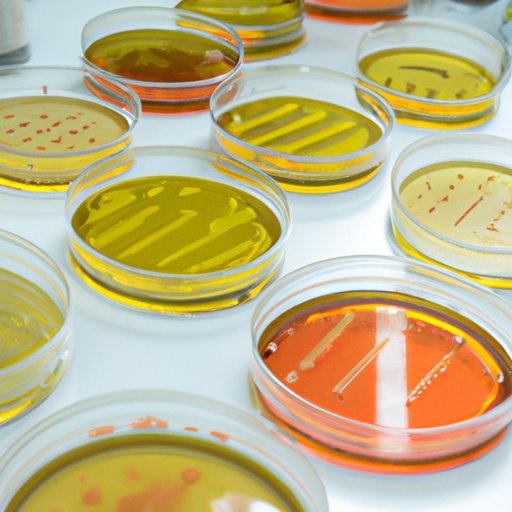

In a world where screens have become the dominant feature of our lives however, the attraction of tangible printed objects hasn't waned. Whatever the reason, whether for education in creative or artistic projects, or simply to add an element of personalization to your area, List Of Media In Microbiology are now an essential source. With this guide, you'll take a dive into the world of "List Of Media In Microbiology," exploring what they are, where they are available, and the ways that they can benefit different aspects of your lives.
Get Latest List Of Media In Microbiology Below

List Of Media In Microbiology
List Of Media In Microbiology - List Of Media In Microbiology, List Of Culture Media In Microbiology Pdf, List Of Selective Media In Microbiology, List Different Types Of Media In Microbiology, List Of Culture Media Used In Microbiology, List Three Types Of Physical Media In Microbiology, What Are The Three Types Of Media In Microbiology, Name Of Media In Microbiology, How Many Types Of Media In Microbiology
List sort cmp None key None reverse False cmp key
C C C STL
List Of Media In Microbiology provide a diverse collection of printable items that are available online at no cost. These resources come in many kinds, including worksheets templates, coloring pages and much more. The benefit of List Of Media In Microbiology is in their variety and accessibility.
More of List Of Media In Microbiology
Specimen Collection Medical Laboratory Scientist MLS

Specimen Collection Medical Laboratory Scientist MLS
List of List copyOf List unmodifiable List
List append obj 2 list count obj 3 list extend seq 4
List Of Media In Microbiology have risen to immense popularity because of a number of compelling causes:
-
Cost-Efficiency: They eliminate the necessity to purchase physical copies of the software or expensive hardware.
-
Flexible: We can customize printed materials to meet your requirements whether you're designing invitations or arranging your schedule or even decorating your home.
-
Educational Value Downloads of educational content for free offer a wide range of educational content for learners of all ages. This makes them a useful tool for parents and teachers.
-
An easy way to access HTML0: Quick access to a variety of designs and templates, which saves time as well as effort.
Where to Find more List Of Media In Microbiology
Bacterial Culture Media classification And Types Of Bacterial Media

Bacterial Culture Media classification And Types Of Bacterial Media
Python List list Python list
List sort key None reverse False key
Since we've got your interest in printables for free Let's find out where you can find these gems:
1. Online Repositories
- Websites like Pinterest, Canva, and Etsy provide a large collection with List Of Media In Microbiology for all purposes.
- Explore categories like the home, decor, management, and craft.
2. Educational Platforms
- Forums and websites for education often provide worksheets that can be printed for free, flashcards, and learning tools.
- Ideal for teachers, parents, and students seeking supplemental resources.
3. Creative Blogs
- Many bloggers share their creative designs and templates free of charge.
- The blogs covered cover a wide range of interests, everything from DIY projects to party planning.
Maximizing List Of Media In Microbiology
Here are some unique ways that you can make use use of printables that are free:
1. Home Decor
- Print and frame gorgeous images, quotes, or other seasonal decorations to fill your living spaces.
2. Education
- Use printable worksheets for free to enhance learning at home, or even in the classroom.
3. Event Planning
- Make invitations, banners and other decorations for special occasions like birthdays and weddings.
4. Organization
- Keep your calendars organized by printing printable calendars including to-do checklists, daily lists, and meal planners.
Conclusion
List Of Media In Microbiology are a treasure trove of practical and imaginative resources for a variety of needs and passions. Their accessibility and flexibility make these printables a useful addition to both personal and professional life. Explore the plethora of printables for free today and unlock new possibilities!
Frequently Asked Questions (FAQs)
-
Are List Of Media In Microbiology truly for free?
- Yes, they are! You can download and print these tools for free.
-
Does it allow me to use free printing templates for commercial purposes?
- It's determined by the specific usage guidelines. Always check the creator's guidelines prior to printing printables for commercial projects.
-
Are there any copyright concerns with List Of Media In Microbiology?
- Certain printables could be restricted regarding usage. Check the terms and conditions offered by the designer.
-
How do I print printables for free?
- Print them at home using printing equipment or visit a print shop in your area for top quality prints.
-
What program must I use to open printables that are free?
- The majority are printed with PDF formats, which can be opened with free programs like Adobe Reader.
Types Of Culture Media In Microbiology RBR Life Science

List Of Culture Media Used In Microbiology With Their Uses

Check more sample of List Of Media In Microbiology below
Explain The Different Types Of Culture Media Amya has Stewart

Bacterial Growth On Culture Media Stock Image C029 1373 Science

Microbiology Culture Media Chart

Agar Plate Summary Medium Appearance Differential Ingredients

Microbiology New Discoveries CULTURE MEDIA AND ITS TYPES USED UN

Colony Characteristics Of Bacteria Introduction Types And Special Feature

https://www.runoob.com › python-list-slicing.html
My list 2 5 2 5 2 5 5 sub list
C C C STL
My list 2 5 2 5 2 5 5 sub list

Agar Plate Summary Medium Appearance Differential Ingredients

Bacterial Growth On Culture Media Stock Image C029 1373 Science

Microbiology New Discoveries CULTURE MEDIA AND ITS TYPES USED UN

Colony Characteristics Of Bacteria Introduction Types And Special Feature

Different Types Of Media Used In Microbiology Labs

Anaerobic Culture Media Microbe Online

Anaerobic Culture Media Microbe Online

Pin By Gerrettcollymore On Bio Exam 1 In 2020 Microbiology Study